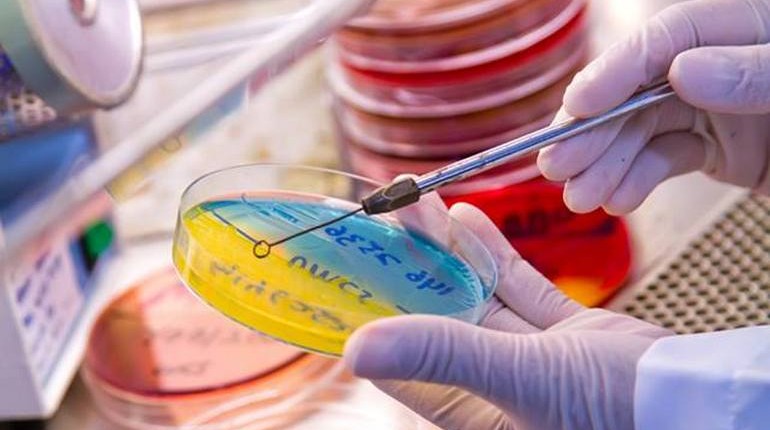

Mikrobiyoloji, mikroorganizmaları inceleyen temel biyolojik bir bilim dalıdır. Mikro; çok küçük (gözle görülemeyecek kadar küçük), -biyo; canlı ve –loji; bilim anlamına gelir. Mikrobiyoloji, mikroorganizmaların çeşitliliği ve evrimi toprak, su, insan ve hayvan vücudu ile bitkilerde bulunan mikroorganizma faaliyetleriyle ilgilenir.
Mikrobiyolojinin konusunu ve kapsamını mikroorganizmalar oluşturur. Mikroorganizma, tek hücreli ve mikroskobik canlılardır. Yüksek organizmaların hücreleri doğada tek başlarına yaşayamaz. Bunun aksine mikroorganizmaların çoğu gelişme, enerji üretimi ve çoğalma gibi yaşamsal işlevlerini diğer hücrelerden bağımsız olarak tek başlarına yapar.
Mikroorganizmalar Üç Grupta İncelenir
- Prokaryotik hücre yapısına sahip olanlar: Bakteriler, Arkeler
- Ökaryotik hücre yapısına sahip olanlar: Mantarlar (Funguslar), Küfler, Mayalar, Protozoa, Algler
- Hücresel yapıya sahip olmayanlar: Virüsler, Viroidler, Prionlar
Mikroorganizma gruplarının genel özellikleri aşağıda verilmiştir:
Bakteri: Hücreleri genellikle çubuk, küresel veya spiral şekillerdedir ancak nadiren köşeli veya yıldızımsı şekillerde olanlara da rastlanmaktadır. Bakteria domaini (âlem üstü kategori) üyelerinde karbonhidrat ve protein kompleksinin oluşturduğu peptidoglikan hücre duvarı bulunmaktadır. Genellikle ikiye bölünme ile çoğalırlar. Pek çoğu beslenme için ölü veya canlı organizmalardan gelen organik bileşikleri kullanır. Bazıları fotosentez yaparken bazıları da inorganik bileşiklerle beslenir. Kamçı adı verilen organeller ile hareket etme yeteneği pek çoğunda vardır. Arkea domaini de Bakteria gibi prokaryotik hücrelerden oluşmuştur. Hücre duvarlarında peptidoglikan bulunmaz. Oldukça tuzlu veya sıcak kükürtlü sular gibi ekstrem (olağan dışı) şartlarda yaşayan bu prokaryotların insanlarda hastalık oluşturduğu bilinmemektedir.
Mantarlar (Funguslar): Ökaryotik organizmalardır. Tek hücreli veya çok hücreli olabilirler. Gerçek mantarların hücre duvarında kitin bulunur. Mantarlar; mayalar, küfler ve şapkalı mantarlar olmak üzere üç farklı grupta incelenir. Mayalar, tek hücreli mantarlar olup bakterilerden oldukça büyük, oval hücrelere sahiptir. Küfler ise misel adı verilen gözle görülür pamuksu veya ipliksi yapıdaki hiflerden oluşmuştur. Mantarlar, eşeyli veya eşeysiz ürer. Besinlerini içinde bulundukları ortamdan absorpsiyon yoluyla alırlar.
Algler: Fotosentez yapan ökaryotik mikroorganizmalardır. Değişik morfolojik yapı gösterirler. Tek hücreli veya filamentli formda olup sulu veya nemli ortamlarda yaşarlar. Yeşil renkli klorofil dışında çeşitli renklerde fotosentetik pigmentler de içerebilirler.
Protozoa: Tek hücreli ve ökaryotik mikroorganizmalardır. Kamçı, yalancı ayak veya sil gibi özel oluşumlar ile hareketlidirler. Protozoa üyeleri çok çeşitli şekillerde olabilir. Serbest veya başka canlılarda parazit olarak yaşarlar. Eşeyli veya eşeysiz ürerler.
Virüsler: Yukarıdaki mikroorganizma gruplarından çok farklıdır. Prokaryot veya ökaryot mikroorganizma değildir. Gerçek bir hücre yapısına sahip değildirler. Yapıları bir çeşit nükleik asit (DNA veya RNA) ve bunu saran bir protein kılıftan ibarettir. Bazılarında protein kılıfı saran bir zarf yapısı da bulunur. Çoğalmak için konak hücre içine girmeleri gerekir. Bu nedenle bir anlamda diğer organizmalarda zorunlu parazit olarak yaşarlar.
Viroidler: Protein içermeyen RNA (Ribonükleik asit) parçacıkları olup bitki hastalıklarına yol açarlar.
Prionlar: Viroidlerin aksine nükleik asit içermeyen ve sadece proteinden ibaret, hayvanlarda merkezi sinir sistemi hastalıkları etmeni olarak tanımlanmış en küçük mikroorganizmalardır.
Mikroorganizmaları çıplak gözle görmek mümkün değildir. Bunun için “mikroskop” adı verilen ve görüntüyü büyütmeye yarayan mercek sistemlerinden yararlanılır.
Mikroorganizmalar çok küçük canlılar olduklarından boyutlarını ifade ederken farklı ölçü birimleri kullanılır. Mikroorganizmaların büyüklüğü tanımlanırken bakteriler, funguslar, protozoa ve algler için mikrometre (μm), virüsler için ise nanometre (nm) birimleri kullanılmaktadır. Mikroorganizmalar büyüklüklerine göre; bakteri > virüs > defektif virüs > viroid > prion olarak sıralansa da bunlardan daha büyük olan protozoa, algler ve mantarlar ise kendi içlerinde değişik büyüklükte olabilir. Işık mikroskobu ile mikrometre boyutlu mikroorganizmalar gözlenebilirken nanometre boyutlu virüslerin gözlenebilmesi için büyütme gücü çok daha fazla olan elektron mikroskoplar kullanılmaktadır. Işık mikroskobu 1 ile 10.000 kat büyütme sağlayabilirken elektron mikroskobu ile 1.000.000 kattan fazla büyütme sağlanabilir. Mikroorganizmaların büyüklüklerini ifade eden ölçülerin dönüşümleri şu şekildedir:

Mikrobiyolojinin Alt Dalları
Mikrobiyoloji iki temel konu üzerine odaklanmıştır:
- Mikroorganizmaların temel yaşam işlevlerini anlamak (Temel mikrobiyoloji)
- Mikrobiyolojiyi insanların yararına olacak şekilde uygulamak (Uygulamalı mikrobiyoloji)
Mikrobiyolojinin bu iki temel konusu farklı alt dalların doğmasına sebep olmuştur. Mikrobiyolojinin alt dalları ve çalışma konuları aşağıda verilmiştir.
1- Temel Mikrobiyoloji:
Araştırılan mikroorganizmaya göre;
- Bakteriyoloji: Bakterileri inceleyen bilim dalı.
- Mikoloji: Mantarları inceleyen bilim dalı.
- Viroloji: Virüsleri inceleyen bilim dalı.
- Protozooloji: Protozoaları inceleyen bilim dalı.
- Parazitoloji: Parazitleri inceleyen bilim dalı.
Araştırılan süreç veya fonksiyona göre;
- Mikrobiyal Genetik: Mikroorganizmalarda genetik bilginin kontrolü, fonksiyonu ve iletilmesini inceler.
- Mikrobiyal Metabolizma: Mikroorganizmalarda meydana gelen metabolik (yapım ve yıkım) olaylarını inceler.
- Mikrobiyal Ekoloji: Mikroorganizmaların birbiri ve çevresi ile olan ilişkisini inceler.
- Epidemiyoloji: Mikroorganizmaların neden olduğu hastalıkların dağılımını ve sıklığını inceler.
- İmmünoloji: Mikroorganizma enfeksiyonlarına karşı konak canlının kendisini nasıl koruduğunu araştırır.
2- Uygulamalı Mikrobiyoloji
- Gıda Mikrobiyolojisi: Mikroorganizmaların gıdalarda neden olduğu bozulmaları, alınacak önlemleri vb. konuları inceleyenbilim dalı.
- Toprak Mikrobiyolojisi: Toprakta yaşayan mikroorganizmaları, temel madde çevrimlerini, mikrobiyolojik parçalanma vb. konularını araştıran bilim dalı.
- Endüstriyel Mikrobiyoloji: Mikroorganizmalar aracılığı ile yapılan endüstriyel üretimleri inceleyen bilim dalı.
- Tıbbi Mikrobiyoloji: Hastalık yapıcı mikroorganizmaları,enfeksiyon hastalıklarını, alınacak önlemleri vb. konuları inceleyen bilim dalı.
- Veteriner Mikrobiyoloji: Hayvanlarda bulunan mikroorganizmalar, hayvan enfeksiyonlarını vb. konuları inceleyen bilim dalı.
Mikrobiyolojinin Gelişimi
Bilim insanlarının mikrobiyoloji bilimine yaptıkları önemli katkılardan bazıları aşağıdaki tabloda verilmiştir.